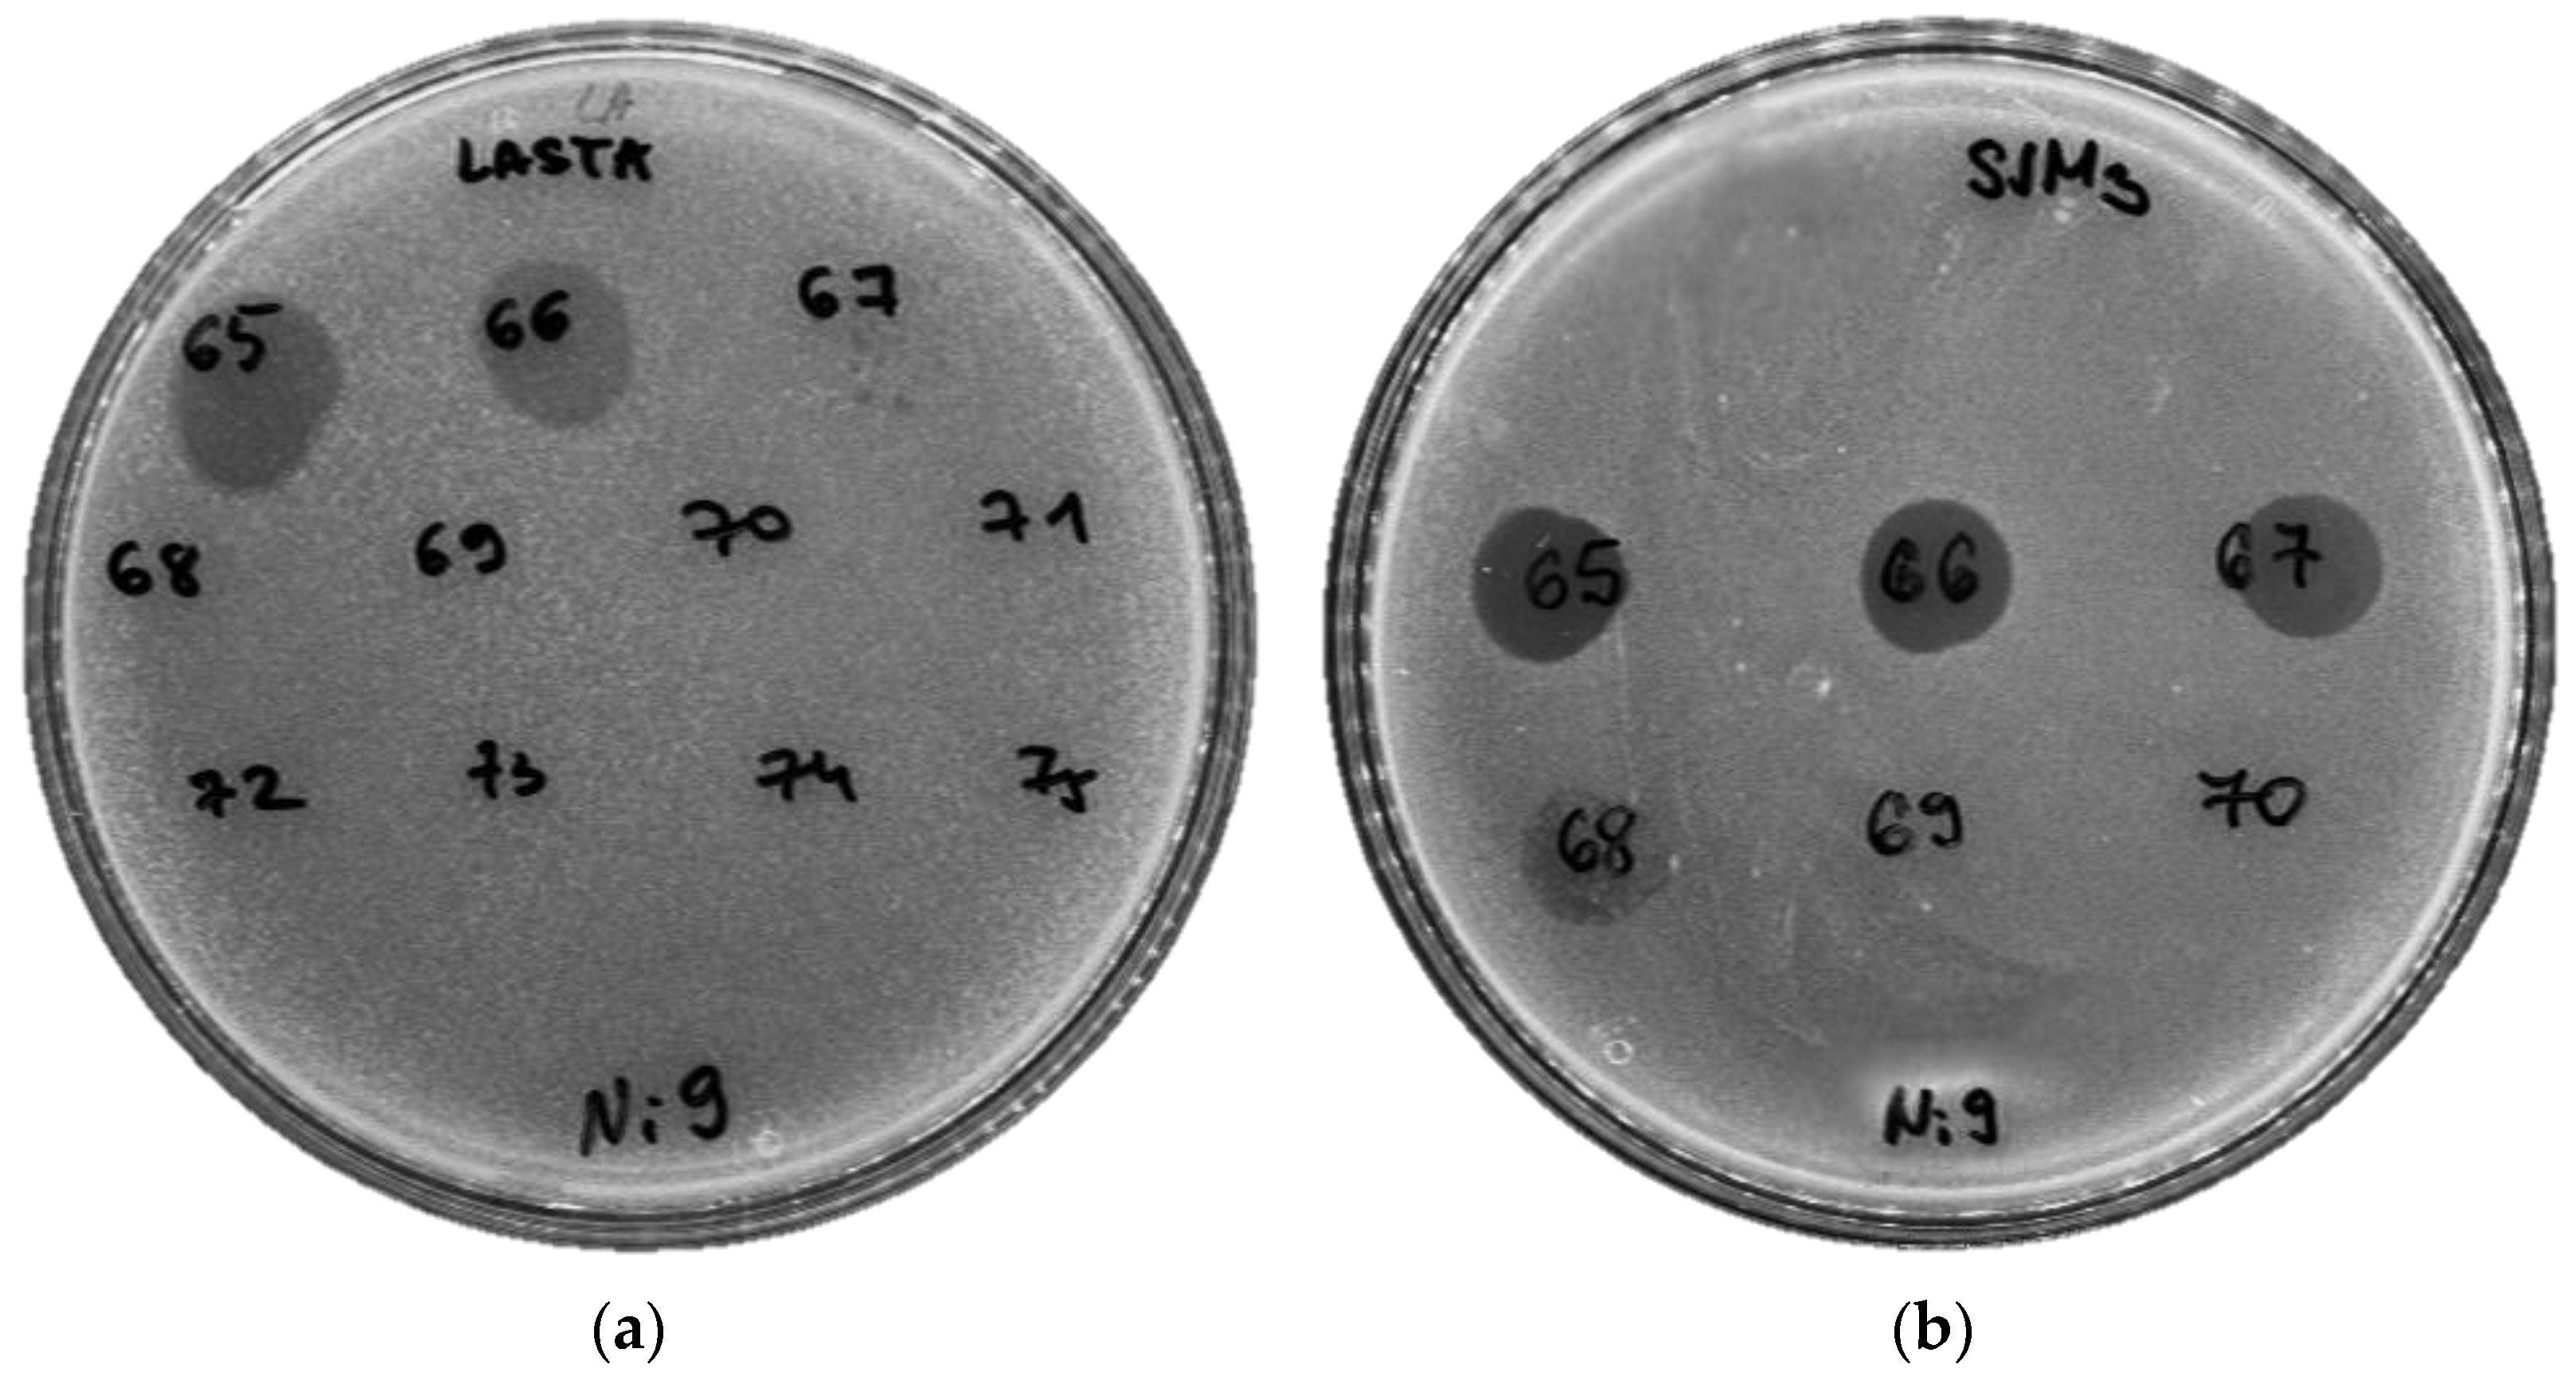
Viruses 15 00628 g006 Viruses 15 00628 g006

Isolation, Characterization, Genome Analysis and Host Resistance Development of Two Novel Lastavirus Phages Active against Pandrug-Resistant Klebsiella pneumoniae
Abstract
1. Introduction
2. Materials and Methods
2.1. Bacterial Strains and Culture Conditions
2.2. Pulsed-Field Gel Electrophoresis
2.3. Phage Isolation, Purification and Propagation
2.4. Transmission Electron Microscopy of Phage Particles
2.5. DNA Extraction and Manipulation
2.6. Genome Sequencing and Bioinformatic Analysis
2.7. Phage Adsorption and One-Step Growth Assay
2.8. Host Range Determination
2.9. Thermal Inactivation of Phages
2.10. The Effect of pH on Phage Stability
2.11. Phage Lytic Activity and Resistant Clone Screening
2.12. Antibiofilm Activity
2.13. Lysogeny Testing
3. Results
3.1. Bacterial Strains
3.2. Phage Isolation, Plaque, and Virion Morphology
3.3. Host Range and Sensitive Strains Analysis
3.4. Adsorption Rate and One-Step Growth Curve
3.5. The Effect of Temperature and pH on Phage Stability
3.6. Phage Lytic Activity
3.7. Antibiofilm Activity
3.8. Resistance Clone Screening
3.9. Lysogeny Testing
3.10. Nucleotide Sequence Accession Number
3.11. Phage Genome Analyses
3.12. Bacterial Genome Analyses
4. Discussion
Supplementary Materials
Author Contributions
Funding
Institutional Review Board Statement
Informed Consent Statement
Data Availability Statement
Acknowledgments
Conflicts of Interest
References
- Antimicrobial Resistance Collaborators. Global burden of bacterial antimicrobial resistance in 2019: A systematic analysis. Lancet 2022, 399, 629–655. [Google Scholar] [CrossRef]
- Bagley, S.T. Habitat association of Klebsiella species. Infect. Control. Hosp. Epidemiol. 1985, 6, 52–58. [Google Scholar] [CrossRef]
- Paczosa, M.K.; Mecsas, J. Klebsiella pneumoniae: Going on the offense with a strong defense. Microbiol. Mol. Biol. Rev. 2016, 80, 629–661. [Google Scholar] [CrossRef]
- Novović, K.; Trudić, A.; Brkić, S.; Vasiljević, Z.; Kojić, M.; Medić, D.; Ćirković, I.; Jovčić, B. Molecular epidemiology of colistin-resistant, carbapenemase-producing Klebsiella pneumoniae in Serbia from 2013 to 2016. Antimicrob. Agents Chemother. 2017, 61, e02550-16. [Google Scholar] [CrossRef]
- Kontopoulou, K.; Protonotariou, E.; Vasilakos, K.; Kriti, M.; Koteli, A.; Antoniadou, E.; Sofianou, D. Hospital outbreak caused by Klebsiella pneumoniae producing KPC-2 β-lactamase resistant to colistin. J. Hosp. Infect. 2010, 76, 70–73. [Google Scholar] [CrossRef]
- Suh, J.Y.; Son, J.S.; Chung, D.R.; Peck, K.R.; Ko, K.S.; Song, J.H. Nonclonal emergence of colistin-resistant Klebsiella pneumoniae isolates from blood samples in South Korea. Antimicrob. Agents Chemother. 2010, 54, 560–562. [Google Scholar] [CrossRef]
- Elemam, A.; Rahimian, J.; Mandell, W. Infection with panresistant Klebsiella pneumoniae: A report of two cases and a brief review of the literature. Clin. Infect. Dis. 2009, 49, 271–274. [Google Scholar] [CrossRef]
- Bogdanovich, T.; Adams-Haduch, J.M.; Tian, G.B.; Nguyen, M.H.; Kwak, E.J.; Muto, C.A.; Doi, Y. Colistin-resistant, Klebsiella pneumoniae carbapenemase (KPC)-producing Klebsiella pneumoniae belonging to the international epidemic clone ST258. Clin. Infect. Dis. 2011, 53, 373–376. [Google Scholar] [CrossRef]
- Jayol, A.; Poirel, L.; Dortet, L.; Nordmann, P. National survey of colistin resistance among carbapenemase-producing Enterobacteriaceae and outbreak caused by colistin-resistant OXA-48-producing Klebsiella pneumoniae, France, 2014. Eurosurveillance 2016, 21, 30339. [Google Scholar] [CrossRef]
- Hyman, P. Phages for phage therapy: Isolation, characterization, and host range breadth. Pharmaceuticals 2019, 12, 35. [Google Scholar] [CrossRef]
- Anand, T.; Virmani, N.; Kumar, S.; Mohanty, A.K.; Pavulraj, S.; Bera, B.C.; Vaid, R.K.; Ahlawat, U.; Tripathi, B.N. Phage therapy for treatment of virulent Klebsiella pneumoniae infection in a mouse model. J. Glob. Antimicrob. Resist. 2020, 21, 34–41. [Google Scholar] [CrossRef]
- Cano, E.J.; Caflisch, K.M.; Bollyky, P.L.; Van Belleghem, J.D.; Patel, R.; Fackler, J.; Brownstein, M.J.; Horne, B.A.; Biswas, B.; Henry, M.; et al. Phage therapy for limb-threatening prosthetic knee Klebsiella pneumoniae infection: Case report and in vitro characterization of anti-biofilm activity. Clin Infect. Dis. 2021, 73, e144–e151. [Google Scholar] [CrossRef]
- Eskenazi, A.; Lood, C.; Wubbolts, J.; Hites, M.; Balarjishvili, N.; Leshkasheli, L.; Askilashvili, L.; Kvachadze, L.; van Noort, V.; Wagemans, J.; et al. Combination of pre-adapted bacteriophage therapy and antibiotics for treatment of fracture-related infection due to pandrug-resistant Klebsiella pneumoniae. Nat. Commun. 2022, 13, 302. [Google Scholar] [CrossRef]
- Hesse, S.; Rajaure, M.; Wall, E.; Johnson, J.; Bliskovsky, V.; Gottesman, S.; Adhya, S. Phage resistance in multidrug-resistant Klebsiella pneumoniae ST258 evolves via diverse mutations that culminate in impaired adsorption. mBio 2020, 11, e02530-19. [Google Scholar] [CrossRef]
- Akusobi, C.; Chan, B.K.; Williams, E.S.; Wertz, J.E.; Turner, P.E. Parallel evolution of host-attachment proteins in phage PP01 populations adapting to Escherichia coli O157: H7. Pharmaceuticals 2018, 11, 60. [Google Scholar] [CrossRef]
- de Leeuw, M.; Baron, M.; Ben David, O.; Kushmaro, A. Molecular insights into bacteriophage evolution toward its host. Viruses 2020, 12, 1132. [Google Scholar] [CrossRef]
- Pan, Y.J.; Lin, T.L.; Chen, C.T.; Chen, Y.Y.; Hsieh, P.F.; Hsu, C.R.; Wu, M.C.; Wang, J.T. Genetic analysis of capsular polysaccharide synthesis gene clusters in 79 capsular types of Klebsiella spp. Sci. Rep. 2015, 5, 15573. [Google Scholar] [CrossRef]
- Li, B.; Zhao, Y.; Liu, C.; Chen, Z.; Zhou, D. Molecular pathogenesis of Klebsiella pneumoniae. Futur. Microbiol. 2014, 9, 1071–1081. [Google Scholar] [CrossRef]
- Yeh, K.M.; Kurup, A.; Siu, L.K.; Koh, Y.L.; Fung, C.P.; Lin, J.C.; Chen, T.L.; Chang, F.Y.; Koh, T.H. Capsular serotype K1 or K2, rather than magA and rmpA, is a major virulence determinant for Klebsiella pneumoniae liver abscess in Singapore and Taiwan. J. Clin. Microbiol. 2007, 45, 466–471. [Google Scholar] [CrossRef]
- Majkowska-Skrobek, G.; Markwitz, P.; Sosnowska, E.; Lood, C.; Lavigne, R.; Drulis-Kawa, Z. The evolutionary trade-offs in phage-resistant Klebsiella pneumoniae entail cross-phage sensitization and loss of multidrug resistance. Environ. Microbiol. 2021, 23, 7723–7740. [Google Scholar] [CrossRef]
- Kropinski, A.M.; Mazzocco, A.; Waddell, T.E.; Lingohr, E.; Johnson, R.P. Enumeration of bacteriophages by double agar overlay plaque assay. Methods Mol. Biol. 2009, 501, 69–76. [Google Scholar]
- Vukotic, G.; Obradovic, M.; Novovic, K.; Di Luca, M.; Jovcic, B.; Fira, D.; Neve, H.; Kojic, M.; McAuliffe, O. Characterization, antibiofilm, and depolymerizing activity of two phages active on carbapenem-resistant Acinetobacter baumannii. Front. Med. 2020, 7, 426. [Google Scholar] [CrossRef]
- Carlson, K. Working with Bacteriophages: Common Techniques and Methodological Approaches. Bacteriophages: Biology and Applications; CRC Press: Boca Raton, FL, USA, 2004; Volume 1, pp. 439–490. [Google Scholar]
- Hoyles, L.; McCartney, A.L.; Neve, H.; Gibson, G.R.; Sanderson, J.D.; Heller, K.J.; van Sinderen, D. Characterization of virus-like particles associated with the human faecal and caecal microbiota. Res. Microbiol. 2014, 165, 803–812. [Google Scholar] [CrossRef]
- Sambrook, J.; Fritsch, E.F.; Maniatis, T. Molecular Cloning: A Laboratory Manual, 2nd ed.; Cold Spring Harbor Laboratory Press: New York, NY, USA, 1989. [Google Scholar]
- Lee, P.Y.; Costumbrado, J.; Hsu, C.Y.; Kim, Y.H. Agarose gel electrophoresis for the separation of DNA fragments. J. Vis. Exp. 2012, 62, e3923. [Google Scholar]
- Peng, Y.; Leung, H.C.; Yiu, S.M.; Chin, F.Y. IDBA-UD: A de novo assembler for single-cell and metagenomic sequencing data with highly uneven depth. Bioinformatics 2012, 28, 1420–1428. [Google Scholar] [CrossRef]
- Li, H.; Durbin, R. Fast and accurate long-read alignment with Burrows-Wheeler transform. Bioinformatics 2010, 26, 589–595. [Google Scholar] [CrossRef]
- Nishimura, Y.; Yoshida, T.; Kuronishi, M.; Uehara, H.; Ogata, H.; Goto, S. ViPTree: The viral proteomic tree server. Bioinformatics 2017, 33, 2379–2380. [Google Scholar] [CrossRef]
- Kleinheinz, K.A.; Joensen, K.G.; Larsen, M.V. Applying the ResFinder and VirulenceFinder web-services for easy identification of acquired antibiotic resistance and E. coli virulence genes in bacteriophage and prophage nucleotide sequences. Bacteriophage 2014, 4, e27943. [Google Scholar] [CrossRef]
- Naville, M.; Ghuillot-Gaudeffroy, A.; Marchais, A.; Gautheret, D. ARNold: A web tool for the prediction of Rho-independent transcription terminators. RNA Biol. 2011, 8, 11–13. [Google Scholar] [CrossRef]
- Lavigne, R.; Sun, W.D.; Volckaert, G. PHIRE, a deterministic approach to reveal regulatory elements in bacteriophage genomes. Bioinformatics 2004, 20, 629–635. [Google Scholar] [CrossRef]
- Lam, M.M.C.; Wick, R.R.; Judd, L.M.; Holt, K.E.; Wyres, K.L. Kaptive 2.0: Updated capsule and lipopolysaccharide locus typing for the Klebsiella pneumoniae species complex. Microb. Genom. 2022, 8, 000800. [Google Scholar] [CrossRef]
- Hyman, P.; Abedon, S.T. Practical methods for determining phage growth parameters. In Bacteriophages: Methods and Protocols: Isolation, Characterization, and Interactions; Humana Press: New York, NY, USA, 2009; Volume 1, pp. 175–202. [Google Scholar]
- Kropinski, A.M. Practical advice on the one-step growth curve. In Bacteriophages: Bacteriophages: Methods and Protocols; Humana Press: New York, NY, USA, 2018; pp. 41–47. [Google Scholar]
- Gašić, K.; Obradović, M.; Kuzmanović, N.; Zlatković, N.; Ivanović, M.; Ristić, D.; Obradović, A. Isolation, characterization and draft genome analysis of bacteriophages infecting Acidovorax citrulli. Front. Microbiol. 2022, 12, 4072. [Google Scholar] [CrossRef] [PubMed]
- Ben-David, A.; Davidson, C.E. Estimation method for serial dilution experiments. J. Microbiol. Methods 2014, 107, 214–221. [Google Scholar] [CrossRef]
- Tkhilaishvili, T.; Lombardi, L.; Klatt, A.B.; Trampuz, A.; Di Luca, M. Bacteriophage Sb-1 enhances antibiotic activity against biofilm, degrades exopolysaccharide matrix and targets persisters of Staphylococcus aureus. Int. J. Antimicrob. Agents 2018, 52, 842–853. [Google Scholar] [CrossRef]
- Tkhilaishvili, T.; Wang, L.; Tavanti, A.; Trampuz, A.; Di Luca, M. Antibacterial efficacy of two commercially available bacteriophage formulations, staphylococcal bacteriophage and PYO bacteriophage, against methicillin-resistant Staphylococcus aureus: Prevention and eradication of biofilm formation and control of a systemic infection of Galleria mellonella larvae. Front. Microbiol. 2020, 11, 110. [Google Scholar] [PubMed]
- Li, P.; Ma, W.; Shen, J.; Zhou, X. Characterization of novel bacteriophage vb_kpnp_zx1 and its depolymerases with therapeutic potential for K57 Klebsiella pneumoniae infection. Pharmaceutics 2022, 14, 1916. [Google Scholar] [CrossRef]
- Walker, P.J.; Siddell, S.G.; Lefkowitz, E.J.; Mushegian, A.R.; Adriaenssens, E.M.; Alfenas-Zerbini, P.; Davison, A.J.; Dempsey, D.M.; Dutilh, B.E.; García, M.L.; et al. Changes to virus taxonomy and to the International Code of Virus Classification and Nomenclature ratified by the International Committee on Taxonomy of Viruses. Arch. Virol. 2021, 166, 2633–2648. [Google Scholar] [CrossRef] [PubMed]
- Abedon, S.T.; Danis-Wlodarczyk, K.M.; Alves, D.R. Phage therapy in the 21st century: Is there modern, clinical evidence of phage-mediated efficacy? Pharmaceuticals 2021, 14, 1157. [Google Scholar] [CrossRef]
- Kortright, K.E.; Chan, B.K.; Koff, J.L.; Turner, P.E. Phage therapy: A renewed approach to combat antibiotic-resistant bacteria. Cell Host Microb. 2019, 25, 219–232. [Google Scholar] [CrossRef]
- Suh, G.A.; Lodise, T.P.; Tamma, P.D.; Knisely, J.M.; Alexander, J.; Aslam, S.; Barton, K.D.; Bizzell, E.; Totten, K.M.C.; Campbell, J.L.; et al. Considerations for the use of phage therapy in clinical practice. Antimicrob. Agents Chemother. 2022, 66, e0207121. [Google Scholar] [CrossRef]
- Verma, V.; Harjai, K.; Chhibber, S. Restricting ciprofloxacin-induced resistant variant formation in biofilm of Klebsiella pneumoniae B5055 by complementary bacteriophage treatment. J. Antimicrob. Chemother. 2009, 64, 1212–1218. [Google Scholar] [CrossRef]
- Townsend, E.M.; Kelly, L.; Gannon, L.; Muscatt, G.; Dunstan, R.; Michniewski, S.; Sapkota, H.; Kiljunen, S.J.; Kolsi, A.; Skurnik, M.; et al. Isolation and characterization of Klebsiella phages for phage therapy. Phage 2021, 2, 26–42. [Google Scholar] [CrossRef]
- Ibarra-Chávez, R.; Hansen, M.F.; Pinilla-Redondo, R.; Seed, K.D.; Trivedi, U. Phage satellites and their emerging applications in biotechnology. FEMS Microbiol. Rev. 2021, 45, fuab031. [Google Scholar] [CrossRef]
- Labrie, S.J.; Samson, J.E.; Moineau, S. Bacteriophage resistance mechanisms. Nat. Rev. Microbiol. 2010, 8, 317–327. [Google Scholar] [CrossRef]
- Wugeditsch, T.; Paiment, A.; Hocking, J.; Drummelsmith, J.; Forrester, C.; Whitfield, C. Phosphorylation of Wzc, a tyrosine autokinase, is essential for assembly of group 1 capsular polysaccharides in Escherichia coli. J. Biol. Chem. 2001, 276, 2361–2371. [Google Scholar] [CrossRef]
- Pan, Y.J.; Lin, T.L.; Chen, Y.H.; Hsu, C.R.; Hsieh, P.F.; Wu, M.C.; Wang, J.T. Capsular types of Klebsiella pneumoniae revisited by wzc sequencing. PLoS ONE 2013, 8, e80670. [Google Scholar] [CrossRef]
- Bertozzi Silva, J.; Storms, Z.; Sauvageau, D. Host receptors for bacteriophage adsorption. FEMS Microbiol. Lett. 2016, 363, fnw002. [Google Scholar] [CrossRef]
- Dams, D.; Brøndsted, L.; Drulis-Kawa, Z.; Briers, Y. Engineering of receptor-binding proteins in bacteriophages and phage tail-like bacteriocins. Biochem. Soc. Trans. 2019, 47, 449–460. [Google Scholar] [CrossRef]
- Taslem Mourosi, J.; Awe, A.; Guo, W.; Batra, H.; Ganesh, H.; Wu, X.; Zhu, J. Understanding bacteriophage tail fiber interaction with host surface receptor: The key “blueprint” for reprogramming phage host range. Int. J. Mol. Sci. 2022, 23, 12146. [Google Scholar] [CrossRef]
- Garcia-Doval, C.; van Raaij, M.J. Structure of the receptor-binding carboxy-terminal domain of bacteriophage T7 tail fibers. Proc. Natl. Acad. Sci. USA 2012, 109, 9390–9395. [Google Scholar] [CrossRef]
- Melnikov, S.; Mailliot, J.; Rigger, L.; Neuner, S.; Shin, B.S.; Yusupova, G.; Dever, T.E.; Micura, R.; Yusupov, M. Molecular insights into protein synthesis with proline residues. EMBO Rep. 2016, 17, 1776–1784. [Google Scholar] [CrossRef]
- Juturu, V.; Wu, J.C. Microbial cellulases: Engineering, production and applications. Renew. Sustain. Energy Rev. 2014, 33, 188–203. [Google Scholar] [CrossRef]

| LASTA vs. SJM3 | Nucleotide Substitution | Amino Acid Substitution | Position (bp) | Supposed Function (Based on Protein Alignment) |
| 1 | G to A | E toG | 15 299 | Tail fiber domain protein |
| 2 | T to C | Lto F | 15 516 | Tail fiber domain protein |
| 3 | G to T | Qto K | 23 041 | Hypothetical protein |
| 4 | C to T | Tto P | 24 852 | T7-like tail fiber |
| 5 | C to T | Fto L | 25 119 | T7-like tail fiber |
| 6 | C to T | D to N | 25 182 | T7-like tail fiber |
| 7 | A to G | Gto S | 25 902 | T7-like tail fiber |
| 8 | T to G | Sto N | 25 996 | T7-like tail fiber |
| 9 | C to A | Lto F | 26 320 | Endoglucanase E1 |
| 10 | C to T | = | 35 146 | Portal protein |
| 11 | A to G | Lto P | 46 275 | DNK methyltransferase HindIII |
| 12 | T to C | = | 51 307 | Hypothetical protein |
| 13 | T to C | = | 53 257 | Hypothetical protein |
Disclaimer/Publisher’s Note: The statements, opinions and data contained in all publications are solely those of the individual author(s) and contributor(s) and not of MDPI and/or the editor(s). MDPI and/or the editor(s) disclaim responsibility for any injury to people or property resulting from any ideas, methods, instructions or products referred to in the content. |
© 2023 by the authors. Licensee MDPI, Basel, Switzerland. This article is an open access article distributed under the terms and conditions of the Creative Commons Attribution (CC BY) license (https://creativecommons.org/licenses/by/4.0/).
Share and Cite
Obradović, M.; Malešević, M.; Di Luca, M.; Kekić, D.; Gajić, I.; McAuliffe, O.; Neve, H.; Stanisavljević, N.; Vukotić, G.; Kojić, M. Isolation, Characterization, Genome Analysis and Host Resistance Development of Two Novel Lastavirus Phages Active against Pandrug-Resistant Klebsiella pneumoniae. Viruses 2023, 15, 628. https://doi.org/10.3390/v15030628
Obradović M, Malešević M, Di Luca M, Kekić D, Gajić I, McAuliffe O, Neve H, Stanisavljević N, Vukotić G, Kojić M. Isolation, Characterization, Genome Analysis and Host Resistance Development of Two Novel Lastavirus Phages Active against Pandrug-Resistant Klebsiella pneumoniae. Viruses. 2023; 15(3):628. https://doi.org/10.3390/v15030628
Chicago/Turabian StyleObradović, Mina, Milka Malešević, Mariagrazia Di Luca, Dušan Kekić, Ina Gajić, Olivia McAuliffe, Horst Neve, Nemanja Stanisavljević, Goran Vukotić, and Milan Kojić. 2023. "Isolation, Characterization, Genome Analysis and Host Resistance Development of Two Novel Lastavirus Phages Active against Pandrug-Resistant Klebsiella pneumoniae" Viruses 15, no. 3: 628. https://doi.org/10.3390/v15030628
APA StyleObradović, M., Malešević, M., Di Luca, M., Kekić, D., Gajić, I., McAuliffe, O., Neve, H., Stanisavljević, N., Vukotić, G., & Kojić, M. (2023). Isolation, Characterization, Genome Analysis and Host Resistance Development of Two Novel Lastavirus Phages Active against Pandrug-Resistant Klebsiella pneumoniae. Viruses, 15(3), 628. https://doi.org/10.3390/v15030628





